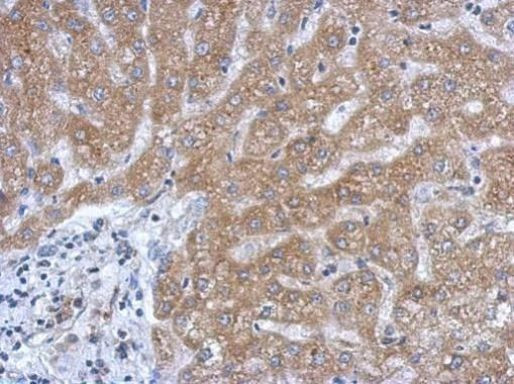
SLC27A2 Antibody in Immunohistochemistry (Paraffin) (IHC (P))

Search
Invitrogen
SLC27A2 Polyclonal Antibody
{{$productOrderCtrl.translations['antibody.pdp.commerceCard.promotion.promotions']}}
{{$productOrderCtrl.translations['antibody.pdp.commerceCard.promotion.viewpromo']}}
{{$productOrderCtrl.translations['antibody.pdp.commerceCard.promotion.promocode']}}: {{promo.promoCode}} {{promo.promoTitle}} {{promo.promoDescription}}. {{$productOrderCtrl.translations['antibody.pdp.commerceCard.promotion.learnmore']}}
产品信息
PA5-30420
宿主/亚型
分类
类型
抗原
偶联物
形式
浓度
规格
保存条件
运输条件
RRID
产品详细信息
Recommended positive controls: 293T, mouse liver, rat liver.
Predicted reactivity: Mouse (88%), Rat (87%), Pig (90%), Bovine (87%).
Store product as a concentrated solution. Centrifuge briefly prior to opening the vial.
靶标信息
The protein encoded by this gene is an isozyme of long-chain fatty-acid-coenzyme A ligase family. Although differing in substrate specificity, subcellular localization, and tissue distribution, all isozymes of this family convert free long-chain fatty acids into fatty acyl-CoA esters, and thereby play a key role in lipid biosynthesis and fatty acid degradation. This isozyme activates long-chain, branched-chain and very-long-chain fatty acids containing 22 or more carbons to their CoA derivatives. It is expressed primarily in liver and kidney, and is present in both endoplasmic reticulum and peroxisomes but not in mitochondria. Its decreased peroxisomal enzyme activity is in part responsible for the biochemical pathology in X-linked adrenoleukodystrophy.
⚠WARNING: This product can expose you to chemicals including mercury, which is known to the State of California to cause birth defects or other reproductive harm. For more information go to www.P65Warnings.ca.gov.
仅用于科研。不用于诊断过程。未经明确授权不得转售。